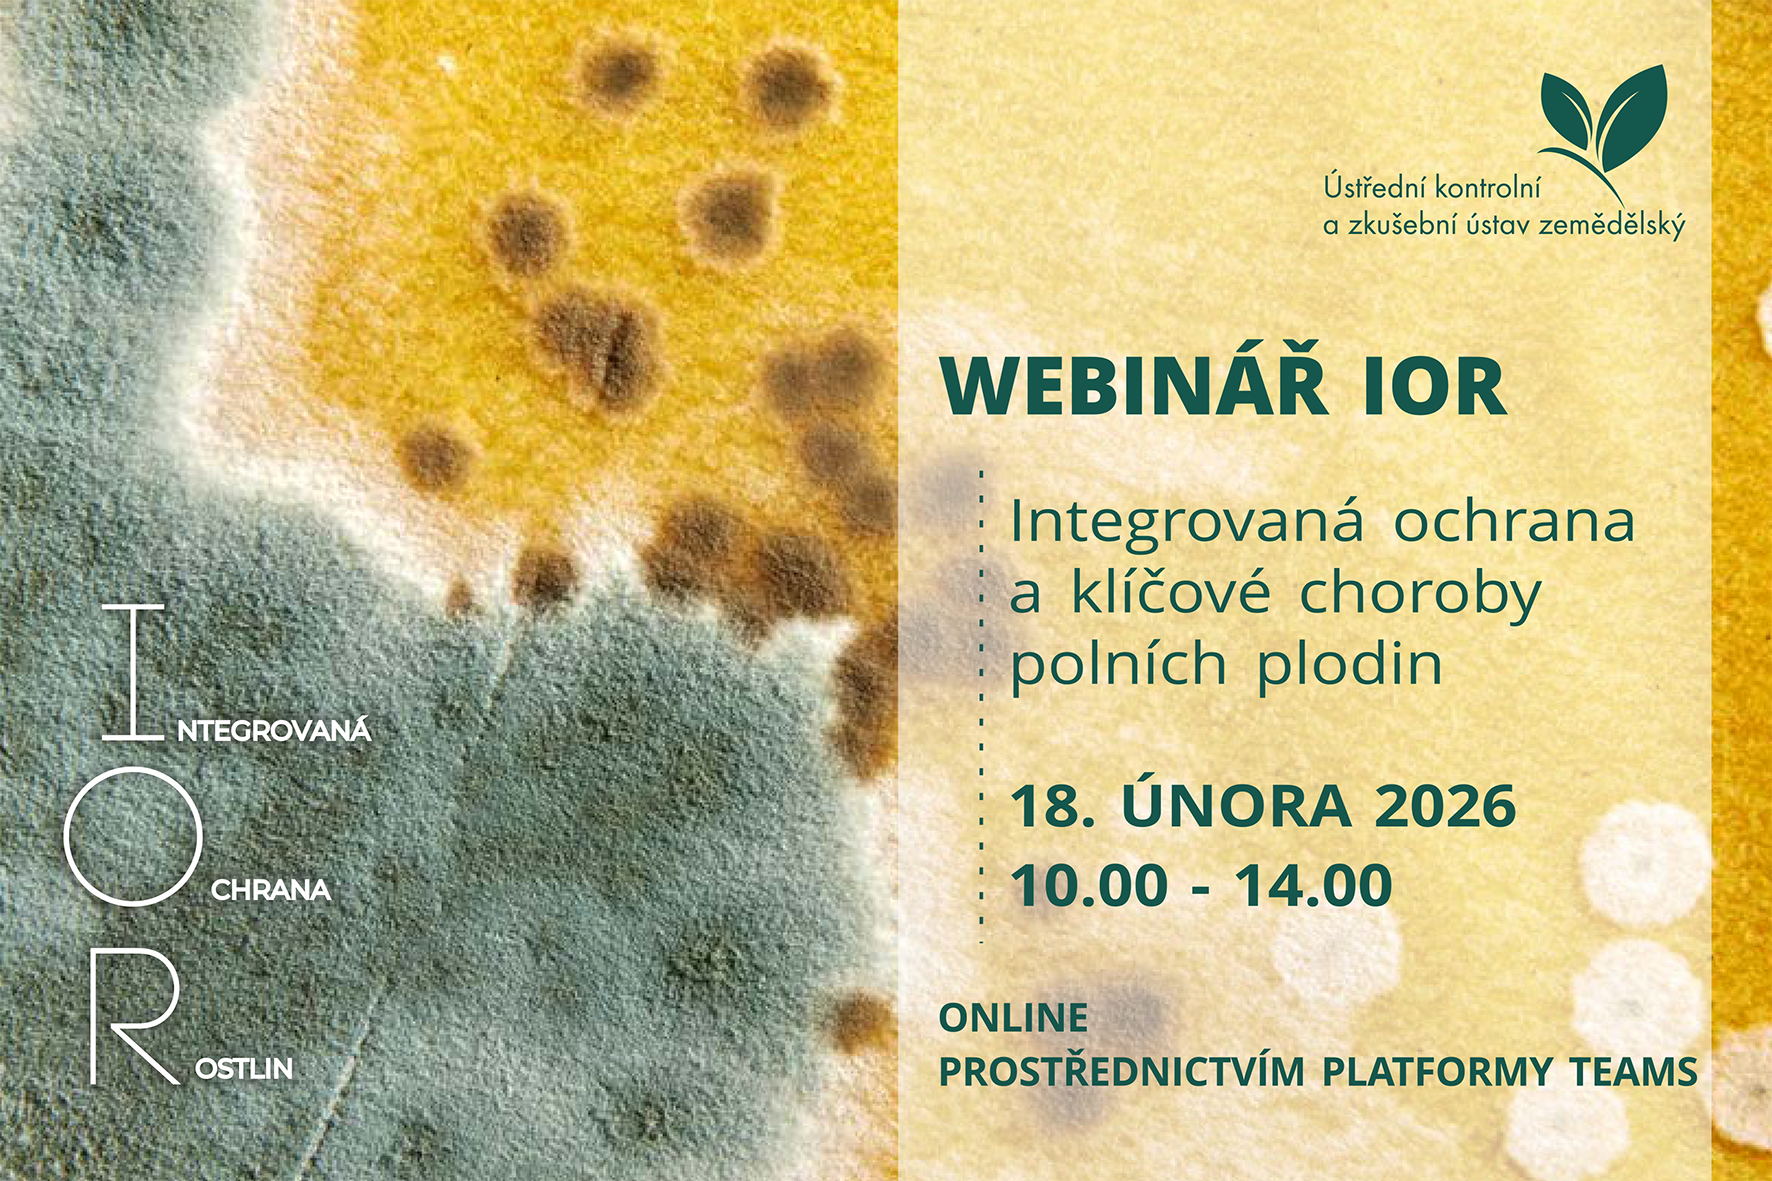

CELOSTÁTNÍ PŘEHLÍDKA POLNÍCH POKUSŮ ODRŮD ZEMĚDĚLSKÝCH PLODIN, OCHRANY A VÝŽIVY ROSTLIN A VÝSTAVA ZEMĚDĚLSKÉ TECHNIKY.
CELOSTÁTNÍ KONTRAKTAČNÍ VÝSTAVY PROFESIONÁLNÍCH STROJŮ S AKTIVNÍM PŘEDVÁDĚNÍM
CELOSLOVENSKÁ PREHLIADKA A VÝSTAVA ODRÔD, OCHRANY A VÝŽIVY RASTLÍN, POĽNOHOSPODÁRSKEJ TECHNIKY A HOSPODÁRSKYCH ZVIERAT

Ústřední kontrolní a zkušební ústav zemědělský
zve na webinář na téma
Integrovaná ochrana rostlin využívá všechny metody regulace škodlivých organismů, zohledňovány jsou ekologické, ekonomické, toxikologické i hygienické požadavky. Záměrem je udržet populace škodlivých organismů na tolerovatelné úrovni, kde nezpůsobují významné hospodářské škody. Využití chemické ochrany při regulaci škodlivých organismů samozřejmě není vyloučeno, k jejímu použití by nicméně mělo dojít až poté, co selžou všechna ostatní opatření, která mají přispět k ochraně porostů pěstovaných rostlin, a která se dostala z různých důvodů do pozadí.
Odborný webinář s názvem: „Integrovaná ochrana a klíčové choroby polních plodin“ navazuje na námi pořádaný webinář o klíčových škůdcích polních plodin a v cyklu přednášek zaměřených na integrovanou ochranu rostlin je celkem již jedenáctý v pořadí.
Cílem letošního webináře je představit klíčové choroby hlavních polních plodin, stručně si připomenout jejich životní cyklus a zejména se zaměřit na způsoby jejich regulace ve smyslu preventivních postupů a biologické či botanické ochrany. Součástí webináře bude i připomenutí funkcí filtrů semaforu přípravků na ochranu rostlin Rostlinolékařského portálu.
Přihlašování na akci probíhá prostřednictvím registračního formuláře.
Program akce připravujeme. Aktuální i nové informace najdete na našich stránkách.
Těšíme se na viděnou.
Tradiční setkání pěstitelů máku v roce 2026.
Tradiční setkání pěstitelů máku v roce 2026.
Ústřední kontrolní a zkušební ústav zemědělský
zve na webinář na téma
Integrovaná ochrana rostlin využívá všechny metody regulace škodlivých organismů, zohledňovány jsou ekologické, ekonomické, toxikologické i hygienické požadavky. Záměrem je udržet populace škodlivých organismů na tolerovatelné úrovni, kde nezpůsobují významné hospodářské škody. Využití chemické ochrany při regulaci škodlivých organismů samozřejmě není vyloučeno, k jejímu použití by nicméně mělo dojít až poté, co selžou všechna ostatní opatření, která mají přispět k ochraně porostů pěstovaných rostlin, a která se dostala z různých důvodů do pozadí.
Odborný webinář s názvem: „Integrovaná ochrana a klíčové choroby polních plodin“ navazuje na námi pořádaný webinář o klíčových škůdcích polních plodin a v cyklu přednášek zaměřených na integrovanou ochranu rostlin je celkem již jedenáctý v pořadí.
Cílem letošního webináře je představit klíčové choroby hlavních polních plodin, stručně si připomenout jejich životní cyklus a zejména se zaměřit na způsoby jejich regulace ve smyslu preventivních postupů a biologické či botanické ochrany. Součástí webináře bude i připomenutí funkcí filtrů semaforu přípravků na ochranu rostlin Rostlinolékařského portálu.
Přihlašování na akci probíhá prostřednictvím registračního formuláře.
Program akce připravujeme. Aktuální i nové informace najdete na našich stránkách.
Těšíme se na viděnou.
Aktuální informace z ÚKZÚZ v oblasti ochrany rostlin
České šlechtění vojtěšek a jetelů – tradice, kvalita, výsledky
Síla pícnin začíná u osiva – travní směsi TRAVAMAN
Posouváme hranice šlechtění – nabídka obilnin RAGT
Zhodnocení pěstitelského ročníku 2024/25 očima rostlinolékaře a výhled do nové sezony
Tradiční cyklus seminářů VVS k problematice zkrmování kvalitních objemných krmiv.
Přihláška zde:
https://vvs.ecomailapp.cz/public/form/14-6094cedc595ae47c2d7e76e9362bf8d4